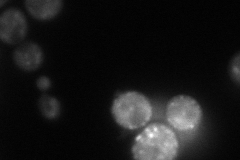
YNL297C
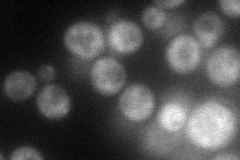
YNL297C
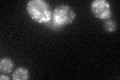
YNL297C

View description
Peripheral membrane protein with a role in endocytosis and vacuole integrity, interacts with Arl1p and localizes to the endosome; member of the Sec7p family of proteins
Localization:
Intensity:
Fold change:
Significance:
-
C’ GFP library in SD

punctate35.06 -
N' NOP1pr-GFP in SD
cytosol,punctate60.2308 -
N' TEF2pr-mCherry in SD
cytosol,punctate65.773 -
N' NATIVEpr-GFP in SD

punctate24.2913 -
N' TEF2pr-VC and Cyto-VN in SD

#N/A0 -
C’ GFP library in SD+DTT
punctate30.570.87No -
C’ GFP library in SD+H2O2

punctate38.71.1No -
C’ GFP library in Starvation Media

punctate35.971.02No -
C’ GFP library on the background of Pup2-DaMP

punctate -
C’ GFP library on the background of CCT mutant

punctate29.31640.836042No
